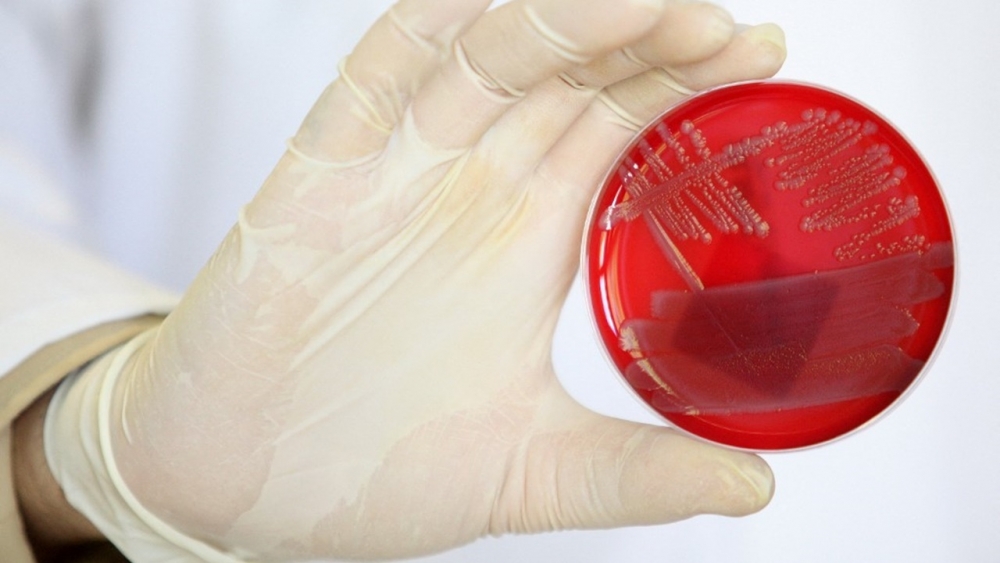

#SootinClaimon.Com : ขอบคุณแหล่งข้อมูล : หนังสือพิมพ์ไทยรัฐ
https://www.thairath.co.th/news/foreign/2478766
22 ส.ค. 2565 03:45 น.
กรมควบคุมโรคสหรัฐฯ เผย เชนร้านอาหารฟาสต์ฟู้ดชื่อดังมีส่วนเชื่อมโยงกับการระบาดของเชื้ออีโคไล ใน 4 รัฐ ซึ่งทำให้มีผู้ป่วยแล้ว 37 ราย
สำนักข่าว ซีเอ็นเอ็น รายงานว่า ศูนย์ควบคุมและป้องกันโรคสหรัฐฯ (CDC) เปิดเผยเมื่อช่วงสุดสัปดาห์ที่ผ่านมา ว่า ร้านอาหาร ‘เวนดีส์’ เชนร้านฟาสต์ฟู้ดชื่อดังของสหรัฐฯ มีส่วนเชื่อมโยงกับการระบาดของเชื้อแบคทีเรีย ‘อีโคไล’ (E.coli) ใน 4 รัฐ ซึ่งทำให้มีผู้ป่วย 37 คน และต้องเข้าโรงพยาบาล 10 ราย
CDC ไม่ได้เจาะจงว่าอาหารชีวิตใดเป็นพาหะของการระบาด แต่มีรายงานว่า ผู้ป่วย 22 จาก 26 คนทานแซนด์วิชที่ร้านเวนดีส์ในรัฐ มิชิแกน, โอไฮโอ และเพนซิลเวเนีย ก่อนจะล้มป่วย
เพื่อเป็นการป้องกันไว้ก่อน ร้านเวนดีส์จึงมีคำสั่งหยุดใช้ ผักกาดโรเมน (romaine) ในแซนด์วิชของพวกเขา เพราะผู้ป่วยส่วนใหญ่ทานแซนด์วิชที่มีผักชนิดนี้ นอกจากนั้น ผักชนิดนี้ยังเคยถูกระบุว่าเป็นพาหะทำให้เกิดการระบาดครั้งใหญ่ของ อีโคไล ใน 35 รัฐของสหรัฐฯ เมื่อปี 2561 มาแล้ว ซึ่งในครั้งนั้นมีผู้เสียชีวิต 5 ศพ
อย่างไรก็ตาม CDC ไม่ได้ออกคำแนะนำให้ประชาชนหลีกเลี่ยงการทานอาหารที่ร้านเวนดีส์ หรือแนะนำให้หยุดทานผักกาดโรเมนแต่อย่างใด โดยพวกเขากำลังสืบสวนเพื่อยืนยันว่า ผักกาดชนิดนี้เป็นต้นตอของการระบาดในครั้งนี้หรือไม่ และว่าซัพพลายเออร์ที่ขายผักกาดโรเมนให้ร้านเวนดีส์ ขายให้แก่ธุรกิจอื่นๆ หรือไม่
ทั้งนี้ ในการระบาดครั้งล่าสุด พบผู้ติดเชื้อ 19 รายที่รัฐโอไฮโอ, 15 รายที่รัฐมิชิแกน, 2 รายที่รัฐเพนซิลเวเนีย และอีก 1 รายที่รัฐอินเดียนา โดยผู้ป่วย 3 รายที่รัฐมิชิแกนมีอาการที่เรียกว่า ‘กลุ่มอาการเม็ดเลือดแดงแตก-ยูรีเมีย’ (hemolytic uremic syndrome) ซึ่งเกิดจากการติดเชื้ออีโคไลด้วย
